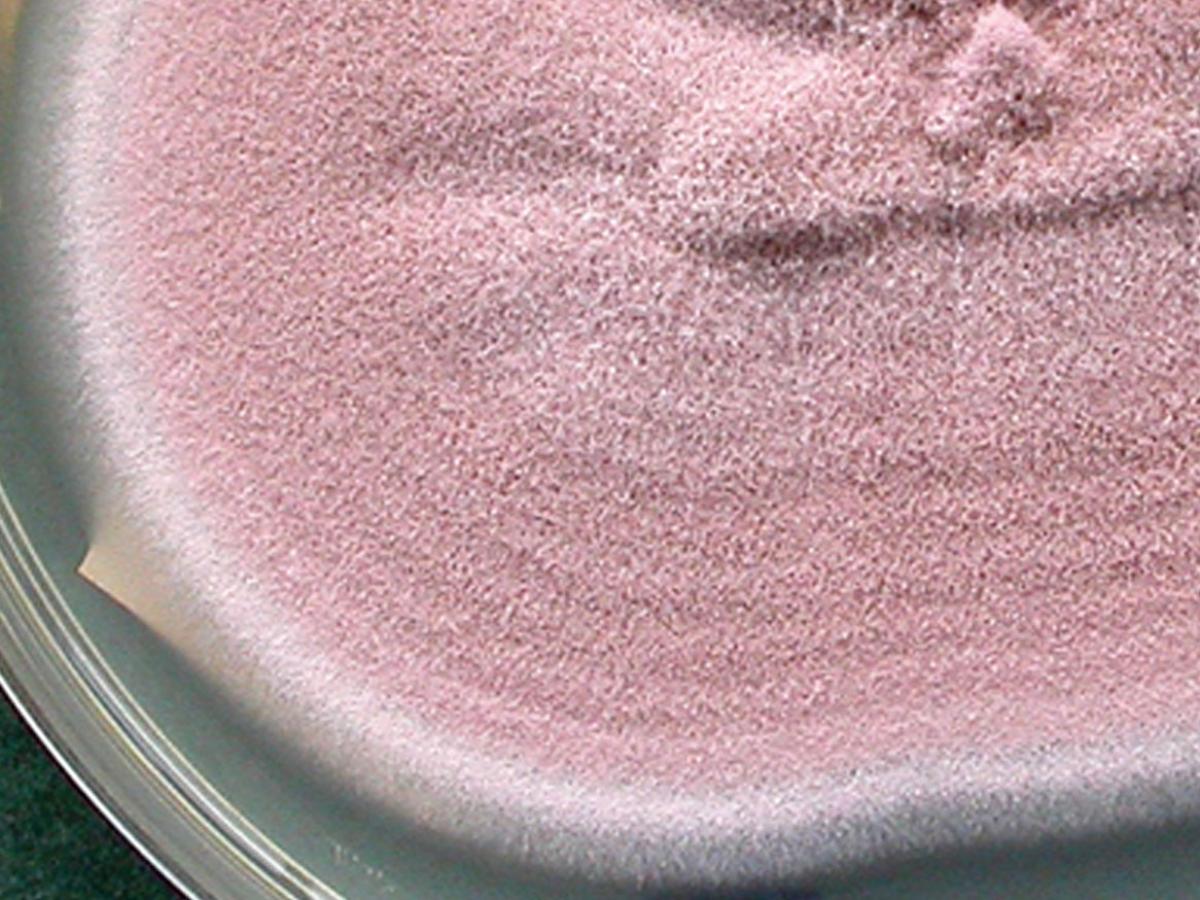
Culture

Status message
Correct! Excellent, you have really done well. Please find additional information below.
Unknown 78 = Trichothecium roseum
Culture: Colonies are moderately fast growing, flat, suede-like to powdery, initially white but becoming rosy, pink or orange with age.
Microscopy: The conidiophores are indistinguishable from the vegetative hyphae until the first conidium is produced. They are erect, unbranched, often septate near the base, more or less rough-walled, bearing basipetal zig-zag (alternating) chains of conidia at the apex. Note the conidiophore is progressively shortened with the formation of each conidium i.e. retrogressive conidial development. Conidia are two celled (didymoconidia), ellipsoidal to pyriform, with an obliquely truncate basal scar, hyaline, smooth to delicately roughened and thick-walled.

Comment: Trichothecium roseum should not be confused with Nannizzia nana. Colonies of the latter may be pinkish-buff in colour and also produce ovoid to pear-shaped, mostly 2-celled macroconidia with thin, verrucose walls. However, N. nana usually produces a red-brown reverse pigment and the 2-celled macroconidia are sessile and formed singly, sometimes on stalks, on undifferentiated conidiophores which do not undergo further change or produce secondary conidia. Note conidia are not produced in basipetal chains as in T. roseum.
Trichothecium roseum has a world-wide distribution and is often isolated from decaying plant substrates, soil, seeds of corn, and food-stuffs (especially flour products). It is occasionally isolated as a saprophyte in the clinical laboratory. RG-1 organism.
About Trichothecium roseum Back to virtual assessment